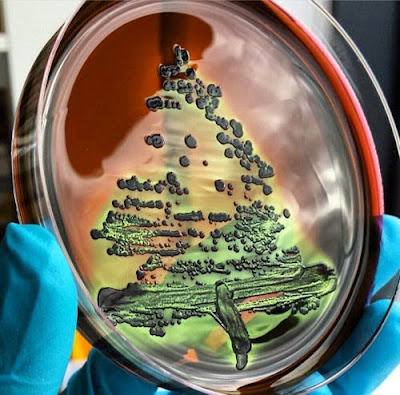

![]() |
| Primjerak genetički modifikovanog duhana koji svijetli u mraku.Izvor: glowingplant.com |
Sve je veći broj amatera-hobista koji se bave tzv. „garažnom“ biotehnologijom ili, kako to Amerikanci, skloni akronimima, vole nazivati „DIY“ – „do it yourself“ biotehnologijom. U svojim improviziranim laboratorijama oni rade, govore sve što se radi i u visokospecijaliziranim „mainstream“ laboratorijama univerzitetskih instituta i biotehnoloških korporacija.
Mali „kućni“ laboratorij može se napraviti za sumu od nekoliko hiljada dolara, pri čemu je imperativ na improvizaciji svega onoga što se može improvizovati – kao inkubator na 37oC DIY istraživačima će dobro poslužiti i vlastiti pazuh, dok najveće uloge moraju staviti na profesionalne uređaje (PCR, HPLC, UV – spektrofotometar…) koje mogu kupiti i polovne.
Međutim, stigma biohazarda nije mimoišla ni ovaj pokret. I kako bi, kada sama ideja da neko, možda, u svom podrumu ili kuhinji pravi neki eksperiment čiji bi krajnji ishod mogao biti neki izuzetno opasan patogen, ne zvuči umirujuće. Zato je FBI počeo slati svoje agente na konferencije DIY biotehnologa.
![]() |
Projekat „The Glowing Plant“ je bio u žiži interesovanja američke javnosti, jer je demonstrirao napore ljudi koji se bave DIY biotehnologijom da pokažu javnosti šta se sve može učiniti sa relativno malo sredstava. DIY biotehnolozi će napraviti i svijetleće pivo ili će koristiti GMO kako bi napravili neki umjetnički projekat instalaciju.
Također, DIY je odličan pristup promovisanju nauke među djecom – jednostavni ogledi, poput “crtanja” bakterijama na hranljivoj podlozi ili izolacija DNK iz jagoda mogu biti prvi eksperimenti i navesti neko dijete da se zaljubi u STEM područje. Na drugoj strani DIY dijagonale nalaze se različite opasne stvari – od vršnjačkih izazova da ovi eksperimentatori sebi ubrizgaju neki izolovani gen do mogućeg bioterorizma i pojave biohakera.
![]() |
![]() |
| Slike od mikrobioloških kultura |
Danas, DIY biotehnolozima se na jedan klik nalazi ogromno znanje i protokoli koji im trebaju za neki eksperiment te sredstva za to nisu nedostupna. Čak ni finansiranje ovakvih projekata nije nemoguće – postoje mogućnost crowd-fundinga na platformama poput Indiegogo i novac se može skupiti.
Kada je Tristan Roberts u sebe ubrizgao gen za antitijelo N6 koje prema nekim istraživanjima neutralizira HIV, a koje su biosintetizirali njegovi prijatelji, to je bila vrlo neodgovorna odluka. Također, za razliku od nauke kakvu znamo, u ovim “kuhinjskim eksperimentima” DIY naučnici ne rade opis metode i postupka, tako da mi ne možemo biti siguri da li su učinili to što tvrde i prema njihovim tvrdnjama treba biti – skeptičniji nego inače.
![]() |
| Tristan Roberts |
Supersoničan razvoj biotehnologije i biologije uopšte iznjedrio je još jedan subverzivni pokret. Biohakeri vjeruju da ništa nije nemoguće za njih. Oni mogu provaliti u baze podataka biotehnoloških korporacija i ukrasti podatke o identitetu pacijenata ili donora uzoraka ćelija ili otkriti polisu osiguranja i bankovni račun korisnika medicinske usluge, otvoriti vrata koja se otvaraju samo na određen otisak prstiju i još svašta nešto.